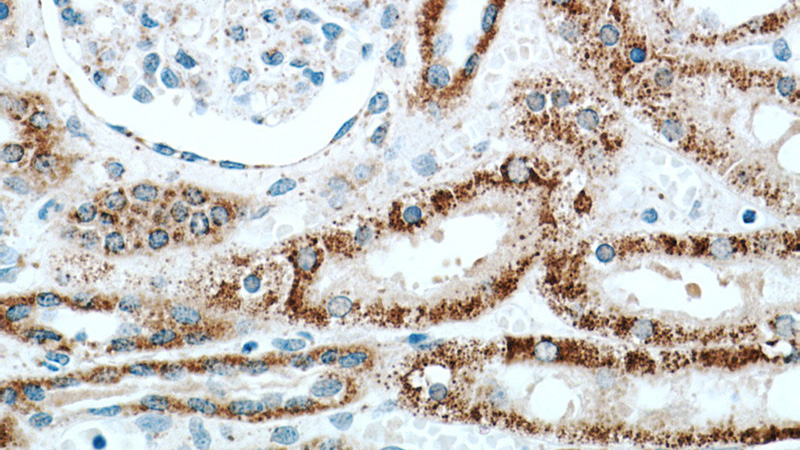
Immunohistochemical of paraffin-embedded human kidney using Catalog No:111845(INPP5J antibody) at dilution of 1:50 (under 40x lens)

-
Product Name
INPP5J antibody
- Documents
-
Description
INPP5J Rabbit Polyclonal antibody. Positive WB detected in human heart tissue, mouse lung tissue. Positive IP detected in mouse lung tissue. Positive IHC detected in human kidney tissue, human heart tissue. Observed molecular weight by Western-blot: 107 kDa,70 kDa
-
Tested applications
ELISA, WB, IHC, IP
-
Species reactivity
Human,Mouse,Rat; other species not tested.
-
Alternative names
INPP5 antibody; INPP5J antibody; PIB5PA antibody; PIPP antibody
-
Isotype
Rabbit IgG
-
Preparation
This antibody was obtained by immunization of INPP5J recombinant protein (Accession Number: NM_001284289). Purification method: Antigen affinity purified.
-
Clonality
Polyclonal
-
Formulation
PBS with 0.02% sodium azide and 50% glycerol pH 7.3.
-
Storage instructions
Store at -20℃. DO NOT ALIQUOT
-
Applications
Recommended Dilution:
WB: 1:200-1:2000
IP: 1:200-1:2000
IHC: 1:20-1:200
-
Validations

human heart tissue were subjected to SDS PAGE followed by western blot with Catalog No:111845(INPP5J antibody) at dilution of 1:500

Immunohistochemical of paraffin-embedded human kidney using Catalog No:111845(INPP5J antibody) at dilution of 1:50 (under 10x lens)
Immunohistochemical of paraffin-embedded human kidney using Catalog No:111845(INPP5J antibody) at dilution of 1:50 (under 40x lens)

IP Result of anti-INPP5J (IP:Catalog No:111845, 4ug; Detection:Catalog No:111845 1:500) with mouse lung tissue lysate 4000ug.
-
Background
INPP5J(Phosphatidylinositol 4,5-bisphosphate 5-phosphatase A) is also named as PIB5PA, PIPP and belongs to the inositol 1,4,5-trisphosphate 5-phosphatase type II family. INPP5J is a key signalling molecule that regulates dendritic outgrowth through activation of small GTPase signalling via interaction between FRMPD4 and ARHGEF7. It can control the resting membrane potential through a specific ion-channel-receptor-ligand interaction that brings about a large conformational change, analogous to neurotransmitter activation of ion channels at synapses. (PMID:22595022). This protein has 3 isoforms produced by alternative splicing.
-
References
- Lin C, Liu A, Zhu J. miR-508 sustains phosphoinositide signalling and promotes aggressive phenotype of oesophageal squamous cell carcinoma. Nature communications. 5:4620. 2014.
- Zhu T, Yuan J, Wang Y, Gong C, Xie Y, Li H. MiR-661 contributed to cell proliferation of human ovarian cancer cells by repressing INPP5J expression. Biomedicine & pharmacotherapy = Biomédecine & pharmacothérapie. 75:123-8. 2015.
Related Products / Services
Please note: All products are "FOR RESEARCH USE ONLY AND ARE NOT INTENDED FOR DIAGNOSTIC OR THERAPEUTIC USE"
